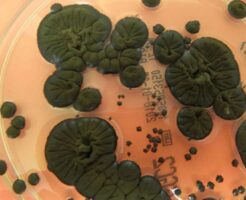

1: それでも動く名無し 2025/12/09(火) 19:01:13.24 ID:ZyNiaMdOr トコ乃〆・クリヤ @Ver11432536 参政党オプチャ、早速人工地震の話題で持ち切りでワロタ 続きを読む Sou・・・
「気になニュー」の記事一覧(8 / 3080ページ目)
チェルノブイリで発見された放射線を食べる真菌、宇宙利用への実験
放射線を食べエネルギーに変える真菌 Image credit:Melanized C. sphaerospermum. チェルノブイリの立ち入り禁止区域で発見された「黒い真菌(カビ)」は、放射線を食べてエネルギーに変え・・・
【レーダー照射事件】中国が飛行訓練していたと主張する海域がこちら
1 名前::2025/12/09(火) 10:45:38.37 ID:otmtPhfa0●.net 7日、空母「遼寧」を含む複数の中国海軍艦艇が、沖縄本島と南大東島の間の海域を北東進していることを確認しました。「遼寧」が・・・
【速報】インターネット(光回線)来年度以降大幅に値上げへ
1 名前::2025/12/09(火) 15:11:31.88 ID:flHK+EP/0●.net 光ファイバ接続料の想定次期算定期間(FY26以降)の接続料は大幅な上昇が見込まれる。 総務省|情報通信審議会 |情報通信・・・
「日の丸にバツ印」掲げた大学生 あいまいな国旗損壊罪に「怖い」 The Mainichi
1 名前:少考さん ★:2025/12/08(月) 22:59:56.66 ID:brXvZhTI9.net 「日の丸にバツ印」掲げた大学生 あいまいな国旗損壊罪に「怖い」https://t.co/lMxUXIRdIZ ・・・
日本のヒーローは幼稚扱いなのに、アメリカのヒーローは幼稚じゃないって風潮、なんなん?
1: 以下、\(^o^)/でVIPがお送りします 2015/04/30(木) 08:11:41.652 ID:/nDTre6i0.net クソアマ「スパイダーマン面白い!仮面ライダーとかガキが見るもの!」 (0H0)「ス・・・
共産・堀川朗子議員「日本は中国大陸を侵略した加害国。中共の台湾侵攻は目をつぶるべき」
1 名前::2025/12/08(月) 21:22:59.80 ID:pSUwbLmx0●.net 共産議員「日本は武力で台湾を奪い、中国大陸を侵略した歴史がある」「日本は植民地支配と侵略戦争の加害国」 高市総理に『存立・・・
日本のお札に使用される紙の材料の9割は、ネパールから輸入されている
通貨とは経済システムの根幹をなすものである。日本であれば「円」がそれにあたり、日本銀行券すなわち紙幣と、補助貨幣である硬貨が流通している。 キャッシュレス化の影響で、その数は減ってきているといわれているが、それでも物・・・
【維新】政治資金でキャバクラやラウンジに支出 奥下議員が釈明21分「今回は返金する」が「ポケットマネーでやるには限界ある」
1 名前:ぐれ ★:2025/12/09(火) 09:40:39.71 ID:qMg/EQg69.net 政治資金でキャバクラやラウンジに支出 維新・奥下議員が釈明21分「今回は返金する」が「ポケットマネーでやるには限界・・・
【東京】玉川高島屋「シャネル」で窃盗容疑 バッグ210万円相当、無職少年(18)逮捕 買い取り店で身分証提示できず売却失敗
1 名前:ぐれ ★:2025/12/08(月) 22:50:35.43 ID:5MWf6OGa9.net 玉川高島屋「シャネル」で窃盗容疑 バッグ210万円相当、少年逮捕―警視庁https://t.co/V4ZlFa9f・・・
【悲報】元ソフトバンクの堂上隼人さん、女性への猥褻容疑で8回目の逮捕
1 名前:それでも動く名無し:2025/12/09(火) 11:30:45.83 ID:mbwlRbFF0.net 【速報】元プロ野球選手(43)を20代女性2人へのわいせつ未遂容疑で8回目の逮捕…これまでの被害者は10・・・
日本「震度6強で30人が軽傷を負いました!!」←これ、地震耐性強すぎやろ
1: 名無しさん@おーぷん 25/12/09(火) 09:38:50 ID:QIVT 地震耐性強すぎやろ大震災にビビり過ぎて南海大地震来ても建物耐えまくって拍子抜けしそうよな 続きを読む Source: 哲学ニュースnw・・・
「謝罪しなければいけないのか?」「(亡くなったのは)不思議」北九州・中学生2人殺傷事件 平原政徳被告(44)が語った謝罪なき心境
1 名前:Hitzeschleier ★:2025/12/09(火) 07:55:48.09 ID:tl4TyZhu9.net JUST IN!! 新着記事⠀ //🗣【独自】「謝罪しなければ・・・
トノサマガエルはスズメバチに刺されても気にせず食べてしまう。痛みや毒はへっちゃら
スズメバチを余裕で食べるトノサマガエル Image credit:Shinji Sugiura, Ecosphere 2025 (DOI: 10.1002/ecs2.70457) (CC BY) スズメバチは狂暴かつ・・・
【結婚の壁】結婚どころか今まで恋愛経験は一切ない人も…「年収500万の壁」を突破できない中間層の苦しい現実
1 名前:ぐれ ★:2025/12/09(火) 08:50:56.66 ID:qMg/EQg69.net 【結婚どころか今まで恋愛経験は一切ない人も…「年収500万の壁」を突破できない中間層の苦しい現実】 #東洋経済オン・・・
一流立憲議員「苺ましまろは醜悪。好きな連中はペドフィリア(小児性愛者)」
1 名前::2025/12/08(月) 21:15:05.07 ID:5p7KBq2+0.net こんなペドフィリアが喜びそうなコンテンツを日本の顔にしないでください。 人の目につかない所で許容される物は、きちんとゾーニ・・・
【広島】「万引きした人を追跡」コンビニ店員の男性(46)を果物ナイフで刺したか 中国籍の少年(17)を殺人未遂容疑で現行犯逮捕
1 名前:ぐれ ★:2025/12/09(火) 07:26:52.30 ID:qMg/EQg69.net /【速報】コンビニ店員の男性(46)を果物ナイフで刺したか 中国籍の少年(17)を殺人未遂容疑で現行犯逮捕 広島\・・・
【悲報】やす子さん、ジャニオタを敵にまわし大炎上するw w w w w w w w w w w w w w w
1 :それでも動く名無し:2025/12/09(火) 02:02:25.81 ID:fcLJ4rZz0.net やす子(27)フジ『呼び出し先生タナカ』にて問題に不正解だったKEY TO LIT 猪狩蒼弥に「猪狩くん、だ・・・
小野田紀美、遂にキレた!「私のXは非公式アカウント!マスコミは私のXを引用するな」ネトウヨ「うむ」
1 :それでも動く名無し:2025/12/08(月) 19:59:27.02 ID:boXcof9e0.net いやこんなんニュースにするのやめてくださいよ。内輪のフォロワー向けに非公式アカウントで呟いているのに呟きや写・・・